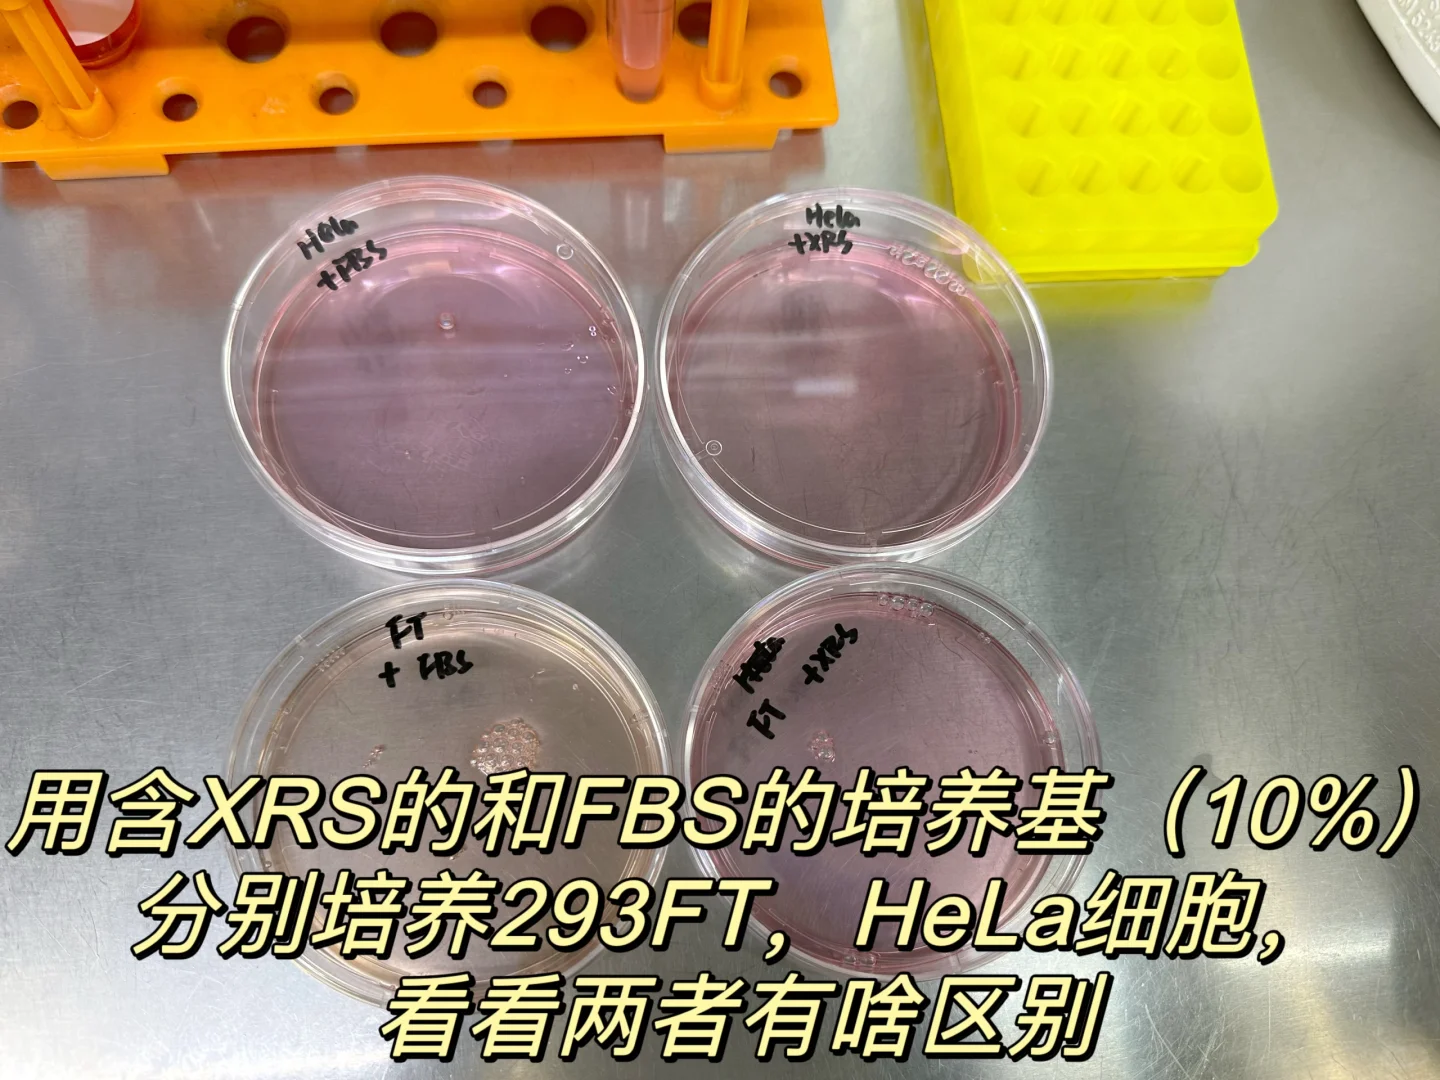

🎃之前出过检测细胞功能实验的汇总(可以翻前面笔记,或者看细胞实验合集),很多同学问应该怎么做,之后我都会陆续分享哒。
🎃今天分享的是Transwell实验的protocol 和tips,以及Transwell涉及的检测细胞迁移和侵袭能力分别怎么做,还有贴壁细胞和悬浮细胞要注意的问题🙋♀️
🎃关于transwell上下室分别都加多少浓度血清的问题,上室最好是无血清的,下室10%~20%范围之内,迁移能力比较弱的细胞建议用20%的,迁移能力强的建议用10%的。
🎃我这里用的是XRS,不是FBS。XRS是近些年新推出的可以替代FBS的培养细胞的产品,我们实验室已经买来使用啦。
✅效果与FBS无差!!不仅效果无差,而且稳定性和价格也越来越亲民!!!泡沫比血清少,用了快一瓶一直用来培养我的贴壁细胞,细胞都长得很好(后面展示了我的细胞状态),而且长得很快,冻存细胞也没有问题!他们家可以申请试用装哦,亲测有效超级好用,有需要的宝子真的可以试试。🤓